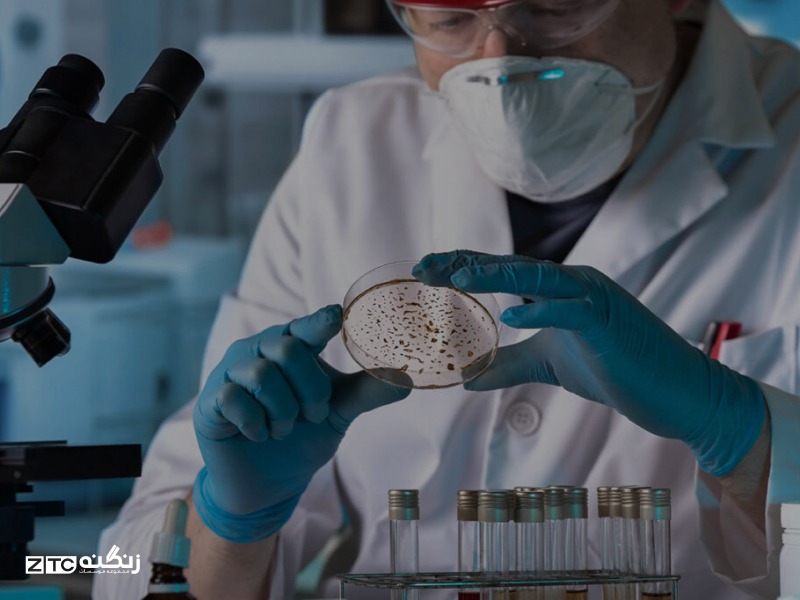
مکالمات کاربردی در مطب پزشک

حتی اگر تصمیم به ثبت نام ندارید...
با پر کردن این فرم یا با تماس با 02145328 صمیمانه و با تمام وجود در کنار شما خواهیم بود.
زمان مطالعه: 12 دقیقه
تاریخ ایجاد: 10 اسفند 1401
تاریخ بروز رسانی: 25 آذر 1404
زمان مطالعه: 12 دقیقه
تاریخ ایجاد: 10 اسفند 1401
تاریخ بروز رسانی: 25 آذر 1404
تصور کنید در یک کشور انگلیسیزبان هستید؛ همه چیز عالی پیش میرود، از مناظر لذت میبرید و زندگی جریان دارد. اما
ناگهان... احساس ناخوشایندی به سراغتان میآید. شاید یک دلدرد ساده باشد یا احساس تب و لرز کنید. در این لحظه حساس،
ندانستن زبان تخصصی میتواند ترسناک باشد. شما نیاز دارید به پزشک مراجعه کنید، اما چگونه باید توضیح دهید که دقیقاً
چه حسی دارید؟ اگر نتوانید انواع بیماری ها و علائم خود را تشریح کنید، تشخیص درست برای پزشک دشوار
خواهد بود.
نگران نباشید! هدف این مقاله دقیقاً همین است. ما قصد داریم شما را با دایره لغات پزشکی در انگلیسی وسیعی از انواع بیماری
ها، علائم فیزیکی، و اصطلاحات بیمارستانی آشنا کنیم تا در هر
شرایطی، بتوانید با اعتمادبهنفس کامل وضعیت سلامتی خود را شرح دهید. دانستن این لغات نه تنها استرس شما را کاهش
میدهد، بلکه میتواند در شرایط اضطراری نجاتبخش باشد.
هفت روز هفته، از ساعت ۸ صبح تا 9 شب
📞 تماس بگیرید: 021-45328

هنگامی که وارد مطب پزشک یا کلینیک میشوید، اولین قدم حفظ آرامش است. استرس میتواند باعث فراموشی لغات شود. پزشک
از شما میپرسد: '?What brings you here today' (امروز برای چه به اینجا آمدهاید؟). در این مرحله باید بتوانید
علائم اولیه را بیان کنید.
در جدول زیر، لیستی از انواع بیماری های رایج و علائم آنها که معمولاً نیاز به بستری طولانیمدت ندارند اما نیازمند
درمان هستند، آورده شده است:
| فارسی | انگلیسی | فارسی | انگلیسی |
|---|---|---|---|
| آلرژی / حساسیت | Allergy | یبوست | Constipation |
| افسردگی | Depression | تب | Fever |
| اسهال | Diarrhea | استخوان شکسته | Broken bone |
| درد (ممتد) | Ache | التهاب | Inflammation |
| درد (تیز/ناگهانی) | Pain | فشار خون بالا | High blood pressure |
| سردرد | Headache | فشار خون پایین | Low blood pressure |
| دل درد | Stomachache | آبریزش بینی | Runny nose |
| گلو درد | Sore throat | احساس ضعف | Feeling weak |
| گوش درد | Earache | سرفه | Cough |
| حالت تهوع | Nausea | عطسه | Sneeze |
| خستگی مفرط | Fatigue | سرگیجه | Dizziness |
نکته کاربردی: برای بیان درد در اعضای مختلف بدن معمولاً از پسوند '-ache' استفاده میکنیم (مانند Headache, Backache, Stomachache). اما برای دردهای ناگهانی یا شدیدتر کلمه 'Pain' رایجتر است (مانند Chest pain).
در حالی که بسیاری از مراجعات پزشکی مربوط به سرماخوردگی یا دردهای جزئی است، گاهی اوقات شرایط بحرانی میشود. شناخت
واژگان مربوط به انواع بیماری های جدی برای تماس با اورژانس (911 در آمریکا یا 999 در انگلستان)
حیاتی است. عدم توانایی در توصیف این شرایط ممکن است عواقب جبرانناپذیری داشته باشد.
جدول زیر شامل بیماریهایی است که اغلب نیاز به مداخله فوری پزشکی یا بستری شدن دارند:
| فارسی | انگلیسی | توضیحات کوتاه |
|---|---|---|
| خونریزی | Haemorrhage | از دست دادن شدید خون از رگها. |
| آپاندیسیت | Appendicitis | التهاب آپاندیس که درد شدید شکمی دارد. |
| نارسایی کلیه | Renal insufficiency | عدم توانایی کلیهها در تصفیه خون. |
| تشنج | Seizure | اختلال ناگهانی در فعالیت الکتریکی مغز. |
| فلج ناشی از لخته خون | Paralysis / Thrombosis | از کار افتادن اندامها به دلیل لخته خون. |
| سکته مغزی | Stroke | قطع جریان خون به بخشی از مغز. |
| کمآبی بدن | Dehydration | کمبود شدید آب در بدن که خطرناک است. |
| آسم | Asthma | بیماری تنفسی که تنفس را دشوار میکند. |
| دیابت | Diabetes | بیماری مربوط به قند خون. |
بیماریهای قلبی یکی از حساسترین گروهها در میان انواع بیماری ها هستند. اگر شما یا همراهتان سابقه بیماری قلبی دارید، پزشکان به اطلاعات بسیار دقیقی نیاز دارند. استفاده از واژگان عمومی در اینجا کافی نیست و باید دقیق باشید.
لیست زیر لغات پزشکی در انگلیسی برای قلب و عروق را پوشش میدهد:
پس از تشخیص انواع بیماری ها، نوبت به مرحله درمان میرسد. شما باید نسخه را دریافت کنید، به داروخانه بروید و دستورالعملهای مصرف دارو را متوجه شوید. در اینجا لیستی از کلمات مرتبط با ابزارها و روشهای درمانی آورده شده است:
| فارسی | انگلیسی | کاربرد |
|---|---|---|
| تزریق / آمپول | Injection / Jab (UK) | روشی برای وارد کردن دارو به بدن. |
| سوزن | Needle | بخش تیز سرنگ. |
| شربت | Syrup | داروی مایع، معمولا برای سرفه یا کودکان. |
| پَد پنبهای | Cotton ball | برای ضدعفونی یا جذب خون. |
| سرنگ | Syringe | ابزار تزریق. |
| مسکن | Painkiller | قرصی برای کاهش درد. |
| دارو | Medicine / Medication | واژه کلی برای هر نوع دارو. |
| چسب زخم | Plaster (UK) / Band-aid (US) | برای پوشاندن زخمهای کوچک. |
| قرص | Pill / Tablet | شکل جامد دارو. |
| درمانگاه / مطب | Clinic | مرکز درمانی کوچکتر از بیمارستان. |
| نسخه | Prescription | برگه دستور دارویی پزشک. |
| التیام دادن | Heal | فرآیند خوب شدن زخم یا بیماری. |
| تشخیص | Diagnosis | نام بیماری که پزشک شناسایی میکند. |
| بانداژ | Bandage | نوار پارچهای برای بستن زخم. |
| زخم | Wound | جراحت روی بدن. |
| گچ گرفتن | Cast | قالبی سفت برای ثابت نگه داشتن استخوان شکسته. |
| اتاق اورژانس | ER (Emergency Room) | بخش فوریتهای پزشکی. |
دانستن نام انواع بیماری ها به تنهایی کافی نیست؛ شما باید بتوانید آنها را در قالب جملات بیان کنید. در ادامه، جملات رایجی که بین پزشک و بیمار رد و بدل میشود را بررسی میکنیم.
برای اینکه پزشک بتواند انواع بیماری ها را به درستی تشخیص دهد، نوع دردی که حس میکنید مهم است. در زبان انگلیسی صفات مختلفی برای درد وجود دارد:
سلامتی مهمترین دارایی ماست و توانایی حفظ آن در هر کجای دنیا اولویت دارد. در این مقاله تلاش کردیم تا شما را با
دایره گستردهای از واژگان مربوط به انواع بیماری ها، از مشکلات گوارشی ساده گرفته تا بیماریهای قلبی پیچیده، آشنا
کنیم. همچنین ابزارهای درمانی و جملات کلیدی برای برقراری ارتباط با کادر درمان را مرور کردیم.
به یاد داشته باشید که در زمان بیماری، استرس بزرگترین دشمن شماست. با تسلط بر این واژگان، میتوانید با
اعتمادبهنفس وارد مطب پزشک شوید، مشکل خود را شرح دهید و با خیالی آسوده روند درمان را طی کنید. توصیه میشود لغات پزشکی در انگلیسی را مرور کنید و حتی جملات کلیدی را در تلفن همراه خود ذخیره کنید تا در مواقع اضطراری در دسترس باشند.
یادگیری زبان انگلیسی فرآیندی است که نیازمند تداوم، منابع معتبر و راهنمایی صحیح است. مقالاتی مانند آنچه
مطالعه کردید، تنها بخش کوچکی از دنیای وسیع زبان را پوشش میده دهند. برای تسلط کامل بر مکالمات روزمره، تخصصی
و آکادمیک، حضور در محیطی آموزشی که ساختاریافته عمل کند، ضروری است.
موسسه آموزشی زنگنه با سالها تجربه درخشان در زمینه آموزش زبانهای خارجی، محیطی را فراهم کرده است که
زبانآموزان میتوانند با اطمینان خاطر و با تکیه بر متدهای روز دنیا، مهارتهای زبانی خود را تقویت کنند.
اساتید مجرب این موسسه با درک نیازهای منحصربهفرد هر دانشجو، مسیر یادگیری را هموار میسازند. چه برای مهاجرت
آماده میشوید، چه برای آزمونهای بینالمللی و چه برای تقویت مکالمه عمومی، موسسه آموزشی زنگنه همراهی مطمئن در
این مسیر خواهد بود.
حتی اگر تصمیم به ثبت نام ندارید...
با پر کردن این فرم یا با تماس با 02145328 صمیمانه و با تمام وجود در کنار شما خواهیم بود.